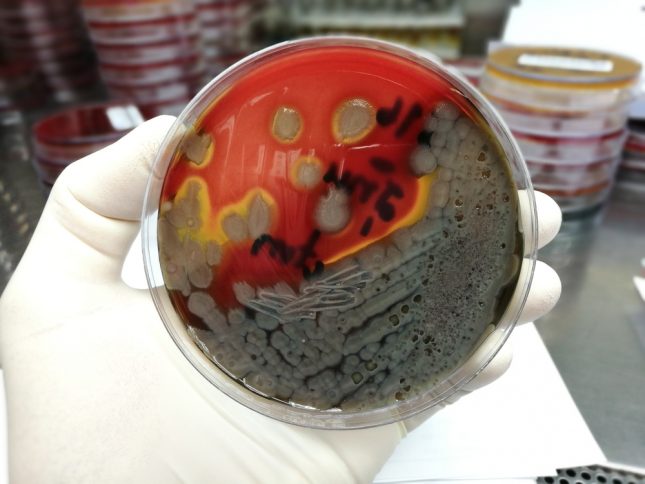

החיידק פסאודומונס אארוגינוזה (P. Aeruginosa) מהווה אתגר משמעותי בטיפול כיוון שהוא עמיד למרבית האנטיביוטיקות המשמשות לטיפול בדלקת ריאות שנרכשה בקהילה (CAP – community-acquired pneumonia). כיום, אין מספיק ידע בנוגע לנטל הכלכלי הגלובלי ולגורמי הסיכון המקושרים ל-CAP כתוצאה מהחיידק.
במחקר הנוכחי, החוקרים העריכו את הנטל הכלכלי העולמי ואת גורמי הסיכון המקושרים ל-P. Aeruginosa-CA.
במחקר נכללו 3,193 מטופלים שאובחנו ב-CAP ועברו בדיקות מיקרוביולוגיות בעת קבלתם לבית החולים. השכיחות חושבה על פי זיהוי של P. Aeruginosa. על מנת לזהות גורמי סיכון ל-P. Aeruginosa- CAP רגיש לאנטיביוטיקה ועמיד לאנטיביוטיקה, בוצעו אנליזות של רגרסיה לוגיסטית.
השכיחות של P. Aeruginosa ושל P. aeruginosa עמיד לאנטיביוטיקה הייתה 4.2% ו-2.0%, בהתאמה. שיעור ה-P. Aeruginosa-CAP בקרב מטופלים עם זיהום/ קולוניזציה קודמים של P. aeruginosa ולפחות מחלת ריאות כרונית בלתי תלויה אחת מתוך שלוש (לדוגמה, טרכאוסטום, ברונכואקטזיות ו/או COPD – chronic obstructive pulmonary disease חמור) עמד על 67%. בשונה מכך, שיעור ה-P. Aeruginosa-CAP בקרב מטופלים ללא זיהום/ קולוניזציה קודמים ב-P. aeruginosa וללא מחלת ריאות כרונית, עמד על 2%.
מסקנות המחקר היו שהשכיחות העולמית של P. Aeruginosa-CAP נמוכה. גורמי הסיכון שזוהו במחקר הנוכחי עשויים להדריך נותני שירות רפואי בקבלת ההחלטות בנוגע למתן טיפול אנטיביוטי אמפירי למטופלים עם CAP.
מקור:
Restrepo, M.I. et al. (2018) European Respiratory Journal 52, 2.